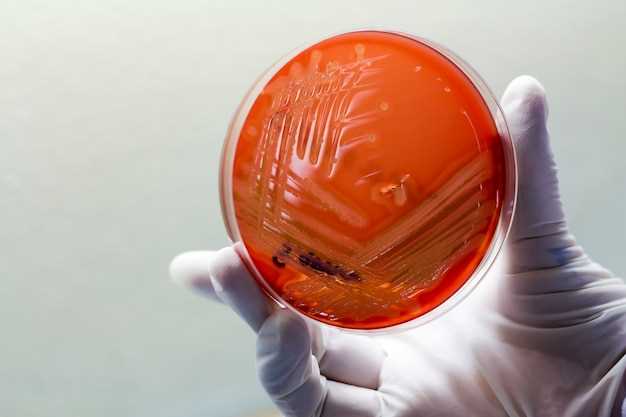
Risks and Side Effects

Saturn clinical trial rosuvastatin
2026-03-17Are you struggling with high cholesterol levels? Looking for a reliable and effective solution to improve your heart health? Look no further than the Saturn Clinical Trial for Rosuvastatin.
Rosuvastatin is a commonly prescribed medication that has been proven to lower cholesterol levels and reduce the risk of cardiovascular events. With the Saturn Clinical Trial, you can get access to this groundbreaking treatment and experience its numerous benefits.
Why choose the Saturn Clinical Trial for Rosuvastatin?
- Expert medical guidance: Our team of experienced doctors and researchers will closely monitor your progress throughout the trial, ensuring your safety and well-being.
- Advanced treatment options: Rosuvastatin is a highly effective statin that has been scientifically proven to lower LDL cholesterol levels and improve heart health. By participating in the Saturn Clinical Trial, you can benefit from this state-of-the-art treatment.
- Access to cutting-edge research: As a participant in the trial, you will have the opportunity to contribute to the advancement of medical knowledge and the development of innovative treatments for cardiovascular diseases.
- Possible financial incentives: In addition to receiving top-quality medical care, participants in the Saturn Clinical Trial may also be eligible for financial compensation.
Don't miss out on this unique opportunity to improve your heart health and contribute to groundbreaking medical research. Join the Saturn Clinical Trial for Rosuvastatin today and take control of your cholesterol levels.
Saturn Clinical Trial Rosuvastatin
The Saturn Clinical Trial is a research study that focuses on the benefits and effects of the medication Rosuvastatin. This trial aims to provide a comprehensive overview of the drug's efficacy and safety in treating various conditions.
Rosuvastatin, also known as a statin, is primarily used to lower cholesterol levels and reduce the risk of cardiovascular diseases such as heart attacks and strokes. It belongs to a class of medications known as HMG-CoA reductase inhibitors, which work by decreasing the production of cholesterol in the liver.
The Saturn Clinical Trial aims to uncover additional benefits of Rosuvastatin beyond cholesterol management. Through this study, researchers seek to evaluate its potential in preventing other cardiovascular events, such as the development of plaque in the arteries or the need for invasive procedures like stenting or bypass surgery.
What are the Objectives of the Saturn Clinical Trial?
- To assess the efficacy of Rosuvastatin in reducing cholesterol levels.
- To investigate the impact of Rosuvastatin on cardiovascular events, such as heart attacks and strokes.
- To evaluate the potential of Rosuvastatin in preventing the progression of atherosclerosis or the formation of plaque in the arteries.
- To assess the safety profile and potential side effects of Rosuvastatin in a diverse population.
The Saturn Clinical Trial is a multicenter study that involves the participation of individuals with varying risk factors and medical backgrounds. Participants will be carefully monitored and provided with the necessary medical care throughout the duration of the trial.
If you are interested in participating in the Saturn Clinical Trial or want to learn more about the study, please contact us using the provided information below.
Contact Information:
Email: trialinfo@saturnstudy.com
Phone: +1-123-456-7890
Saturn Clinical Trial: Overview
At Saturn Clinical Trial, we are conducting a groundbreaking study on the benefits of Rosuvastatin, a highly effective medication for managing cholesterol levels. Our trial aims to investigate the long-term effects of Rosuvastatin on various cardiovascular conditions and its potential benefits for patients.
Why Rosuvastatin?
Rosuvastatin is a widely prescribed medication in the statin class, known for its ability to lower cholesterol levels and reduce the risk of cardiovascular events. Our study focuses on the specific benefits of Rosuvastatin in comparison to other statins, aiming to provide valuable insights into its efficacy and potential side effects.
The Importance of Cholesterol Management
Maintaining healthy cholesterol levels is crucial for overall cardiovascular health. High levels of cholesterol can lead to the formation of plaques in the arteries, increasing the risk of heart disease, stroke, and other serious conditions. By participating in our trial, you can contribute to advancing scientific knowledge and improving treatment options for patients with cholesterol-related disorders.
During the trial, participants will receive close medical supervision and regular check-ups to ensure their safety and well-being throughout the study duration. Our team of experienced researchers and healthcare professionals will closely monitor the participants' cholesterol levels, overall health, and any potential side effects of Rosuvastatin.
Eligibility Criteria
To participate in the Saturn Clinical Trial for Rosuvastatin, individuals must meet certain eligibility criteria, including:
- Age between 40 and 70 years
- Diagnosis of high cholesterol levels
- No previous history of statin medication intolerance
- No history of cardiovascular events (heart attack, stroke, etc.)
If you meet the eligibility criteria and are interested in contributing to scientific research in cholesterol management, we encourage you to apply for our trial and take an active role in advancing medical knowledge.
How to Participate

To participate in the Saturn Clinical Trial for Rosuvastatin, please contact our team via phone or email to schedule an initial assessment. During the assessment, our healthcare professionals will evaluate your eligibility, provide detailed information about the trial, and address any questions or concerns you may have.
Your participation in the Saturn Clinical Trial can make a significant difference in the lives of individuals affected by high cholesterol and cardiovascular diseases. Join us today in our mission to improve the understanding and treatment of these conditions.
Benefits of Rosuvastatin
Rosuvastatin, also known by the brand name Saturn, has several benefits when used in clinical trials:
| 1. Lowering LDL Cholesterol Levels | Rosuvastatin has been proven to effectively reduce levels of LDL cholesterol, also known as "bad" cholesterol, in the body. By reducing LDL cholesterol, Rosuvastatin helps to prevent the build-up of plaque in the arteries and reduce the risk of heart disease and stroke. |
| 2. Increasing HDL Cholesterol Levels | In addition to lowering LDL cholesterol, Rosuvastatin has also been shown to increase levels of HDL cholesterol, also known as "good" cholesterol. Higher levels of HDL cholesterol are beneficial as it helps to remove LDL cholesterol from the bloodstream and reduce the risk of heart disease. |
| 3. Lowering triglycerides | Rosuvastatin can also lower triglyceride levels in the blood. High triglyceride levels can contribute to the development of heart disease and other cardiovascular conditions. By lowering triglycerides, Rosuvastatin helps to improve heart health. |
| 4. Reducing Inflammation | Studies have shown that Rosuvastatin can reduce inflammation in the body. Chronic inflammation is linked to various health problems, including heart disease. By reducing inflammation, Rosuvastatin may help to lower the risk of developing cardiovascular conditions. |
| 5. Preventing Cardiovascular Events | By effectively lowering LDL cholesterol levels, increasing HDL cholesterol levels, reducing triglycerides, and reducing inflammation, Rosuvastatin can help to prevent cardiovascular events such as heart attacks or strokes. |
It is important to note that the benefits may vary for each individual, and it is recommended to consult with a healthcare professional to determine if Rosuvastatin is the right option for you.
Who can Participate
The Saturn Clinical Trial is currently seeking participants who meet the following criteria:
1. Age
- Participants must be 18 years of age or older.
2. Health Condition
- Participants must have been diagnosed with high cholesterol.
- Participants must not have any other significant health conditions.
3. Medications
- Participants must not be currently taking any medication that interacts with rosuvastatin.
- Participants must be willing to discontinue any relevant medications for the duration of the trial.
4. Lifestyle
- Participants must be willing to adhere to a specific diet and exercise plan as instructed by the trial team.
- Participants must not have any lifestyle factors that may significantly impact the trial results, such as heavy alcohol consumption or substance abuse.
If you believe you meet the above criteria and are interested in participating in the Saturn Clinical Trial, please follow the instructions below to apply.
Risks and Side Effects
Before participating in the Saturn Clinical Trial for Rosuvastatin, it is important to be aware of the potential risks and side effects associated with the medication. While Rosuvastatin is generally well-tolerated, it is possible to experience certain adverse effects.
Common side effects of Rosuvastatin include:
- Muscle pain or weakness
- Headache
- Nausea
- Abdominal pain
- Constipation
- Dizziness
It is important to note that these side effects are usually mild and temporary, resolving on their own after the body adjusts to the medication. However, if any of these side effects persist or worsen, it is recommended to consult with your healthcare provider.
In rare cases, serious side effects may occur, including:
- Unexplained muscle pain, tenderness, or weakness
- Jaundice (yellowing of the skin or eyes)
- Dark-colored urine
- Severe abdominal pain
- Signs of allergic reaction (such as rash, itching, swelling, severe dizziness, or trouble breathing)
If you experience any of these serious side effects, it is crucial to seek immediate medical attention.
Keep in mind that the benefits of participating in the Saturn Clinical Trial and potentially receiving the benefits of Rosuvastatin should be weighed against the potential risks. Your healthcare provider can provide further information and help determine if participating in the clinical trial is right for you.
Contact our team for more information and to find out if you qualify to participate in the Saturn Clinical Trial for Rosuvastatin.
Risks and Side Effects
In the Saturn clinical trial for Rosuvastatin, some participants may experience certain risks and side effects. It is important to be aware of these potential effects before deciding to participate in the trial.
Potential Risks:
1. Adverse Reactions: As with any medication, there is a possibility of experiencing adverse reactions to Rosuvastatin. This can include but is not limited to muscle pain, liver problems, kidney problems, and digestive issues. It is important to report any unusual symptoms to the medical staff promptly.
2. Allergic Reactions: Some individuals may be allergic to Rosuvastatin or its components. Signs of an allergic reaction can include hives, difficulty breathing, or swelling of the face, lips, tongue, or throat. If you experience any of these symptoms, seek immediate medical attention.
3. Drug Interactions: Rosuvastatin can interact with other medications you may be taking. These interactions can affect the effectiveness of both medications or lead to unwanted side effects. It is crucial to inform the medical staff of any medications you are currently taking.
Possible Side Effects:
1. Muscle Pain: Some participants may experience muscle pain, weakness, or tenderness while taking Rosuvastatin. This is known as myopathy and can be a sign of a serious side effect. If you notice any such symptoms, inform the medical staff immediately.
2. Headache: Headaches are a common side effect of Rosuvastatin. They are usually mild and go away on their own. However, if you experience severe or persistent headaches, it is essential to consult the medical staff.
3. Digestive Issues: Rosuvastatin can cause digestive problems such as nausea, vomiting, and diarrhea. These side effects are usually temporary and improve over time. If they persist or become severe, discuss them with the medical staff.
It is important to note that not everyone will experience these risks or side effects. The findings from the Saturn clinical trial will help researchers better understand the safety and efficacy of Rosuvastatin. To learn more about the risks and side effects associated with the trial, please contact the medical staff.
Contact Us
If you have any questions or would like more information about the Saturn Clinical Trial or the benefits of participating in our study, please don't hesitate to reach out to us. Our experienced team is here to help and provide you with the support you need.
Phone:
For immediate assistance, please call our toll-free number at 123-456-7890. Our lines are open 24 hours a day, 7 days a week.
Email:
If you prefer to communicate via email, you can send your inquiries to info@saturnclinicaltrial.com. We strive to respond to all emails within 24 hours.
Don't miss out on this incredible opportunity to contribute to medical research and potentially improve your own health. Contact us today to learn more and take the first step towards a healthier future!